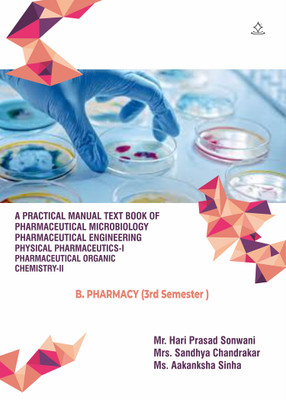
A Practical Manual Text book of Pharmaceutical Microbiology Pharmaceutical Engineering Physical Pharmaceutics-II Pharmaceutical organic chemistry-I - B.Pharmacy (3rd Semester )(Paperback, Mr. Hari Prasad Sonwani, Mrs. Sandhya Chandrakar, Ms. Aakanksha Sinha)

A Practical Manual Text book of Pharmaceutical Microbiology Pharmaceutical Engineering Physical Pharmaceutics-II Pharmaceutical organic chemistry-I - B.Pharmacy (3rd Semester )(Paperback, Mr. Hari Prasad Sonwani, Mrs. Sandhya Chandrakar, Ms. Aakanksha Sinha)
Quick Overview
Product Price Comparison
Practical microbiology is a field of study that involves the practical application of microbiology, including laboratory work, experiments, and the use of equipment: ŌĆó Laboratory work This includes preparing and sterilizing equipment and culture media, preparing microbial cultures, inoculating media, incubating cultures, and sampling during growth. ŌĆó Experiments Practical microbiology involves performing experiments, such as dissections and preparing permanent slides. ŌĆó Equipment Practical microbiology involves using equipment such as microscopes and laboratory reagents. Some topics covered in practical microbiology include: ŌĆó Identifying common microbes, their classification, and their role ŌĆó Understanding how bacteria become resistant and how to test for antimicrobial susceptibility ŌĆó Learning about the importance of quality management and assurance ŌĆó Covering disease-causing bacteria, bacterial viruses, and the use of phage for treating diseases ŌĆó Learning about the microbiome, gene editing with CRISPR, parasites, fungi, and animal viruses Some books that cover practical microbiology include: ŌĆó Practical Microbiology A concise guide for students of microbiology that includes more than 230 experiments, diagrams, and viva-voce exercises Practical Pharmaceutical Engineering provides readers with the technical information and tools needed to deal with most common engineering issues that can arise in the course of day-to-day operations of pharmaceutical/biotech research and manufacturing. Engineers working in pharma/biotech wear many hats. Practical physical pharmaceutics is a course that helps students understand the physical and physicochemical properties of dosage forms and their principles. It also helps students gain insight into the areas of pharmaceutical dosage form stability studies and formulation research and development.